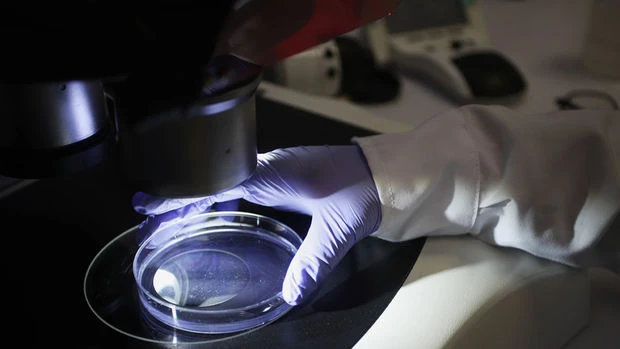
post-slider

Arxiv
Siz burdasınız:
Ana səhifə
Arxiv
Azərbaycan İnvestisiya Holdinqinin Müşahidə Şurasının növbəti iclası keçirilib - FOTO
15:48 12.01.21
Ərdoğan Türkiyədə koronavirusa qarşı vaksinasiya prosesinin başlayacağı tarixi açıqladı
13:19 12.01.21
Ərdoğan: “Türkiyə Dağlıq Qarabağda apardığı mübarizədə Aİ ölkələrindən dəstək almadı”
12:22 12.01.21
Xəbər lenti
Hamısına bax
Karapetyan Azərbaycan və Türkiyə ilə əməkdaşlığa qarşı çıxdı
17:47 01.05.2026
Gündəm
DİM: 6 nəfər imtahandan xaric olunub
17:42 01.05.2026
Elm və Təhsil
Buraxılış imtahanının nəticələri elan olundu
17:40 01.05.2026
Elm və Təhsil
Zelenski: Ukrayna Rusiyanın neft infrastrukturunu darmadağın edir
17:12 01.05.2026
Dünya
Bankların adından kiberdələduzluq edən şəxslər saxlanılıb - VİDEO
16:23 01.05.2026
Hadisə
Qarabağ və ətrafında 1,5 milyondan çox mina təhlükəsi qalır
16:22 01.05.2026
Gündəm
Kartlardan ardıcıl pul çıxılması niyə baş verir? - İZAH GECİKMƏDİ
15:04 01.05.2026
Aktual
İlham Haqverdiyevə hökm oxunub
14:39 01.05.2026
Cəmiyyət
Vətəndaşların müraciətlərinə dair yeni tələblər müəyyənləşir
14:14 01.05.2026
Sosial